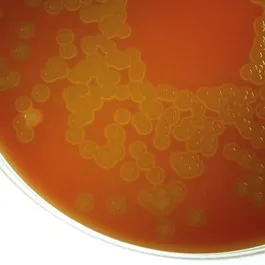

Blood Agar Base
01-352
Nutrient rich medium suitable for the isolation of pathogenic microorganisms from clinical specimens. This medium needs to add Ampicillin Selective Supplement (Art.No.: 06-126LYO1).
This medium needs addition of Blood.
Nutrient rich medium suitable for the isolation of pathogenic microorganisms from clinical specimens. This medium needs to add Ampicillin Selective Supplement (Art.No.: 06-126LYO1).
This medium needs addition of Blood.

01-352
Nutrient rich medium suitable for the isolation of pathogenic microorganisms from clinical specimens. This medium needs to add Ampicillin Selective Supplement (Art.No.: 06-126LYO1).
This medium needs addition of Blood.

Rest of the World
Rest of the World



